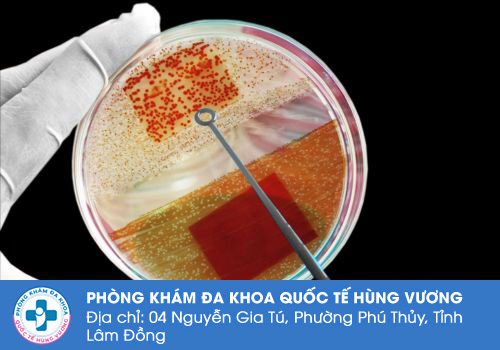

Công ty TNHH MTV dịch vụ y tế Quốc Tế Hùng Vương
4 Nguyễn Gia Tú, Phú Thuỷ, TP. Phan Thiết, Bình Thuận (đ/c cũ)
Liên lạc: 0252.7303.888
Bệnh hạ cam mềm là bệnh lý nhiễm trùng lây nhiễm qua đường tình dục. Đây là bệnh lý khá thường gặp ở cả nam và nữ. Nếu bệnh không được phát hiện sớm và điều trị kịp thời sẽ gây ra nhiều biến chứng nguy hiểm đối với sức khỏe người bệnh.
Trò chuyện cùng chuyên gia để hiểu rõ hơn về bệnh hạ cam
Bệnh hạ cam do vi khuẩn Haemophilus ducreyi gây ra. Đây là một bệnh lây truyền qua đường tình dục, chủ yếu lây lan qua quan hệ tình dục không an toàn.
Các yếu tố nguy cơ và nguyên nhân chính:
Quan hệ với nhiều bạn tình: Tăng nguy cơ lây nhiễm khi có nhiều bạn tình, đặc biệt là trong môi trường mà bệnh hạ cam phổ biến.
Tiếp xúc trực tiếp với vết loét: Vi khuẩn Haemophilus ducreyi có thể lây lan qua tiếp xúc trực tiếp với vết loét hở của người bị nhiễm, bao gồm cả tiếp xúc trong quá trình quan hệ tình dục

Vệ sinh kém: Vệ sinh cá nhân kém, đặc biệt là vệ sinh bộ phận sinh dục, có thể tăng nguy cơ nhiễm bệnh.
Hệ miễn dịch yếu: Những người có hệ miễn dịch suy giảm, chẳng hạn như người bị nhiễm HIV, dễ bị nhiễm bệnh hơn.
Tiếp xúc với dụng cụ không vệ sinh: Sử dụng các dụng cụ y tế, chăm sóc cá nhân hoặc làm đẹp không đảm bảo vệ sinh cũng có thể là nguồn lây nhiễm.
Bệnh hạ cam có một số triệu chứng đặc trưng, chủ yếu xuất hiện ở bộ phận sinh dục, nhưng cũng có thể ở miệng hoặc hậu môn. Các triệu chứng bao gồm:
Vết loét đau
Vết loét thường bắt đầu như một nốt mụn nhỏ, sau đó nhanh chóng phát triển thành vết loét lớn hơn.
Vết loét có bờ không đều, mềm, và dễ chảy máu khi bị chạm vào.
Vết loét có thể xuất hiện đơn lẻ hoặc thành cụm, và có thể rất đau đớn.

Sưng hạch bạch huyết
Hạch bạch huyết vùng bẹn thường bị sưng, đau, và có thể mưng mủ (được gọi là hạch bẹn).
Hạch bẹn có thể phát triển thành áp xe và cần phải được chọc hút hoặc phẫu thuật để làm sạch.
Đỏ sưng và tiết dịch
Khu vực xung quanh vết loét có thể đỏ, sưng và viêm.
Vết loét có thể tiết ra một loại dịch có mùi hôi, gây khó chịu.
Nếu không được chẩn đoán và điều trị kịp thời, bệnh hạ cam có thể dẫn đến nhiều biến chứng nghiêm trọng:
Nhiễm trùng thứ cấp: Vết loét hạ cam có thể bị nhiễm trùng bởi các vi khuẩn khác, gây ra tình trạng nhiễm trùng lan rộng và khó điều trị hơn.
Hình thành sẹo: Các vết loét có thể để lại sẹo xấu, ảnh hưởng đến thẩm mỹ và gây đau đớn lâu dài.

Nguy cơ lây nhiễm HIV tăng cao: Các vết loét hạ cam tạo ra cổng vào dễ dàng cho virus HIV, làm tăng nguy cơ lây nhiễm HIV khi quan hệ tình dục không an toàn với người nhiễm HIV.
Nếu không điều trị kịp thời bệnh sẽ gây ra nhiều biến chứng nguy hiểm, gặp khó khăn trong việc điều trị bệnh. Vì vậy, khi có dấu hiệu lạ thường người bệnh cần chủ động thăm khám để được các chuyên gia tư vấn phác đồ điều trị hạ cam hiệu quả, phù hợp.
Click vào khung chat để được các bác sĩ hỗ trợ
Theo các bác sĩ chuyên khoa Bệnh xã hội - Phòng Khám Đa Khoa Quốc Tế Hùng Vương bệnh hạ cam nếu được phát hiện sớm và điều trị kịp thời, có thể chữa khỏi hẳn hoàn toàn. Trước khi điều trị hạ cam, bác sĩ sẽ yêu cầu người bệnh thực hiện một số xét nghiệm để chẩn đoán nguyên nhân, tình trạng bệnh như sau:
Xét nghiệm mô bệnh học: Đối với những tổn thương bị bội nhiễm và lan rộng, thường cần phải làm sinh thiết để xét nghiệm mô học.
Nhuộm soi tìm trực khuẩn Ducrey: Lấy bệnh phẩm ở dịch chọc hút hạch xoài vùng bẹn, săng hạ cam.
Sau khi có kết quả chẩn đoán tình trạng bệnh hạ cam, bác sĩ sẽ tư vấn phương pháp điều trị bệnh phù hợp với từng tình trạng sức khỏe người bệnh:
Dùng thuốc: Điều trị hạ cam có thể sử dụng thuốc kháng sinh dạng uống, dạng bôi để giúp vết thương mau lành và tránh để lại sẹo. Người bệnh cần sử dụng thuốc theo chỉ định bác sĩ để tránh xảy ra phản ứng thuốc.
.jpg)
Phẫu thuật điều trị: Đối với trường hợp bệnh tạo thành ổ mủ, người bệnh cần thực hiện thủ thuật để giúp giảm tình trạng sưng và đau cũng như làm lành vết loét. Tuy nhiên, trường hợp này khả năng cao sẽ để lại bệnh.
Ngoài việc áp dụng những phương pháp điều trị bệnh tiên tiến, Phòng Khám Đa Khoa Quốc Tế Hùng Vương còn sở hữu những ưu điểm đáng kể đến như sau:
Phòng khám sở hữu đội ngũ bác sĩ có trình độ chuyên môn cao, nhiều năm kinh nghiệm trong ngành.
Cơ sở vật chất hiện đại, hệ thống trang thiết bị theo tiêu chuẩn quốc tế. Môi trường phòng khám khang trang, sạch sẽ với đầy đủ các tiện nghi, đạt tiêu chuẩn.

Tất cả chi phí hỗ trợ điều trị đều được niêm yết công khai, rõ ràng theo đúng quy định.
Thời gian làm việc linh hoạt từ 8h – 20h, kể cả chủ nhật, ngày lễ tết tạo điều kiện thuận tiện cho người bệnh trong quá trình thăm khám và điều trị bệnh.
Mọi thắc mắc, vui lòng liên hệ với Phòng Khám Đa Khoa Quốc Tế Hùng Vương theo cách sau đây
Nhấp vào khung chat dưới đây để nhận được sự tư vấn miễn phí.
Gọi đến số hotline 0252.7303.888 để đặt lịch thăm khám nhanh nhất.
Đến địa chỉ 4 Nguyễn Gia Tú, P. Phú Thuỷ, Tỉnh Lâm Đồng
Click vào bảng tư vấn bên dưới để được hỗ trợ nhé.
Đặt lịch hẹn thăm khám trên KHUNG TƯ VẤN online để ĐƯỢC hưởng ưu đãi:
Phòng Khám Đa Khoa Quốc Tế Hùng Vương địa chỉ: 4 Nguyễn Gia Tú, P. Phú Thuỷ, Tỉnh Lâm Đồng
- Đặt lịch hẹn qua số điện thoại: 0252.7303.888 để được đăng ký khám sớm không mất công chờ đợi.
- Đăng ký ngay để nhận tư vấn và dịch vụ ưu đãi: